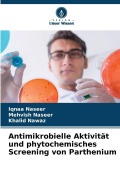
Cover-Bild zum Titel 'Antimikrobielle Aktivität und phytochemisches Screening von Parthenium' von 'Iqnaa Naseer, Mehvish Naseer, Khalid Nawaz'

Welche Arten von Thrillern gibt es?
Unter Thriller-Fans gibt es eine große Spannweite verschiedener Interessen. Hierdurch haben sich zahlreiche Unterkategorien entwickelt. Dazu zählen beispielsweise
- Psychothriller, in deren Zentrum meist die pathologischen Zustände der menschlichen Seele stehen;
- Horrorthriller, deren Autoren oft mit übersinnlichen Elementen arbeiten, um beim Leser Gänsehaut pur zu erzeugen;
- Ökothriller, welche sich literarisch mit dem unverantwortlichen Handeln der Menschheit gegenüber der Umwelt und den Folgen auseinandersetzen;
- Wirtschaftsthriller, die rücksichtsloses Gewinnstreben und kriminelle Ausbeutung zum Thema machen;
- Politthriller, die dem Leser einen Einblick in die kriminellen Strukturen der großen Politik verschaffen;
- Agententhriller, welche einen Blick hinter die Kulissen der großen Geheimdienste erlauben;
- Medizinthriller, die sich um kriminelle Machenschaften aus dem Pharmabereich drehen oder Skandale wie den weltweiten Organhandel ins Visier nehmen;
- Wissenschaftsthriller, die als Ausflüge in Gegenwart und Zukunft der Wissenschaft und Technologie Berührungspunkte mit dem Science Fiction-Genre aufweisen.
- Justizthriller, die den dunklen Raum beleuchten, der sich nicht selten zwischen Recht und Gerechtigkeit auftut.
Häufig finden sich auch literarische Mischformen. So sind Politthriller oft auch Agententhriller, während Medizinthriller Überschneidungen mit Wirtschaftsthrillern aufweisen können. Für den Leser ist die Frage der exakten Einordnung bei neuen Thrillern meist nebensächlich, wenn der Autor es versteht, einen meisterhaften Spannungsbogen zu ziehen, der für ein unvergessliches Leseerlebnis sorgt.
Thriller oder Krimi?
Zahlreiche Berührungspunkte der Genres machen es oft nicht einfach, Thriller und Krimis voneinander abzugrenzen. Tatsächlich gibt es viele Parallelen, aber auch einige Unterschiede, anhand derer die Einordnung gelingt. Welche Merkmale also zeichnen einen neuen Thriller aus?
- Für einen guten Thriller gilt: Atmosphäre ist alles! Beklemmend, bedrohlich, geheimnisvoll oder irrational: Begnadete Schriftsteller bedienen sich zahlreicher Stilmittel, um die gewünschte Grundstimmung eines Romans zu erzeugen und aufrechtzuerhalten.
- Das emotionale Erleben der Protagonisten ist für einen guten Thriller meist wichtiger als das kriminalistisch exakte Ermitteln, das oft im Zentrum von Krimis steht.
- Das Grundthema eines Thrillers geht in seiner Bedeutung oft über den kriminellen Einzelfall hinaus und dreht sich um gesamtgesellschaftliche oder sogar existenzielle Fragen.
- Während in vielen Krimis das jeweilige Ermittlerteam im Zentrum steht, werden Thriller häufiger aus der Sicht eines bösen Protagonisten geschildert.
Auch wenn obige Merkmale tendenziell häufig zutreffen, steht für die meisten Autoren die künstlerische Freiheit im Mittelpunkt, weshalb sie sich natürlich nicht immer an diese Zuordnungen halten. Wenn Sie nach neuen Thrillern suchen, kann es sich deshalb lohnen, auch einen Blick auf die Seite der Krimi Neuerscheinungen zu werfen. Ob Krimi oder Thriller: Wenn Sie Ihre Wunschtitel gefunden haben, dann können Sie die Funktion click & collect dazu nutzen, einen lokalen Anbieter ganz in Ihrer Nähe zu finden, der die gewünschten Bücher auf Lager hat.
Neue Thriller – bekannte Autoren
Im Folgenden möchten wir Ihnen einige bekannte Schriftsteller vorstellen, die ihr Publikum regelmäßig mit neuen Thrillern begeistern. Nutzen Sie unsere Tipps als Einstiegshilfe in die Spannungsliteratur. Oder stöbern Sie eigenständig in den aktuellen Thriller Neuerscheinungen auf dieser Seite. Ein Tipp: Wenn Sie regelmäßig nach neuem Lesestoff suchen, empfehlen wir Ihnen, ein Lesezeichen zu den genialokal Neuerscheinungen in Ihrem Browser zu setzen.
- Sebastian Fitzek – Der Berliner Autor hat sich schon vor Jahren als Verfasser spannender Psychothriller einen Namen gemacht. Inzwischen zeugen zahlreiche Übersetzungen in insgesamt 24 Sprachen von einer beispiellosen Erfolgsgeschichte, die jeden neuen Thriller des Autors mühelos zum Bestseller avancieren lässt.
- Arno Strobel – Er wurde im Saarland geboren und begann erst im Alter von fast vierzig Jahren mit dem Schreiben. Heute gehört der Schriftsteller zu den erfolgreichsten deutschen Thrillerautoren überhaupt, dessen Neuerscheinungen regelmäßig für Begeisterung sorgen.
- Hansjörg Anderegg – Thriller mit wissenschaftlichem Hintergrund, so lautet das Erfolgsrezept des Schweizer Autors Hansjörg Anderegg, der beruflich viele Jahrzehnte als Computerfachmann und Manager tätig gewesen war. Heute nutzt er sein fundiertes Wissen über künstliche Intelligenz und Computernetzwerke als Quelle für packende Geschichten.
- Ethan Cross – Fans des US-amerikanischen Schriftstellers läuft es kalt den Rücken herunter, wenn sie den Namen Francis Ackerman hören: Der Serienkiller steht im Mittelpunkt des Schaffens von Ethan Cross und lässt seine Opfer eintauchen in die finstere Welt von Hass, Zorn, Angst und Schmerz.
- Ursula Poznanski – Die österreichische Schriftstellerin ist durch ihre eigenen Thriller sowie durch die Gemeinschaftswerke mit Bestsellerautor Arno Strobel einem breiten Lesepublikum bekannt geworden. Wenn ihr Salzburger Ermittlerduo Beatrice Kaspary und Florin Wenninger zur Hochform aufläuft, ist anspruchsvolle Thriller-Kost garantiert!
Stöbern Sie auf dieser Seite nach neuen Thrillern. Oder informieren Sie sich über unser Gesamtsortiment der Thriller , wo Sie Ihre Wahl aus über 2.000 Titeln treffen können. Für welches Buch Sie sich auch entscheiden: Nutzen Sie click & collect, und lassen Sie die Lektüre Ihrer Wahl beim regionalen Händler Ihres Vertrauens zur Abholung reservieren!
Häufige Fragen
Kann ich neue Thriller auch im eBook-Format beziehen?
Bei genialokal haben Sie grundsätzlich die freie Wahl zwischen allen verfügbaren Formaten, in denen ein Verlag das jeweilige Buch anbietet. Heute gilt die zeitgleiche Veröffentlichung einer Buchneuerscheinung als eBook als nahezu selbstverständlicher Standard im Verlagswesen. Im Bereich der elektronischen Bücher empfehlen wir unseren Nutzern, auf das System tolino zu setzen, das maximale Freiheit in Bezug auf Dateiformat und Bezugsquellen gewährleistet. Entdecken Sie die aktuellen tolino eReader jetzt bei genialokal und lassen Sie sich diejenigen lokalen Buchhändler anzeigen, über die Sie Ihr Gerät beziehen können. Anschließend ermöglicht Ihnen die komfortable WLAN-Verbindung das sekundenschnelle Kaufen und Herunterladen neuer Thriller und anderer eBooks.
Warum lohnt es sich, ein Nutzerkonto bei genialokal anzulegen?
Mit genialokal können Sie direkt auf den aktuellen Warenbestand von über 600 Buchhändlern in Deutschland zugreifen und sehen mit wenigen Mausklicks, wo Ihr Wunschtitel direkt auf Lager ist. Falls Sie sich noch nicht bei genialokal registriert haben, so empfehlen wir Ihnen, dies gleich heute zu tun. Legen Sie Ihr kostenloses Nutzerkonto an, um ab sofort von allen Vorteilen zu profitieren, die genialokal Ihnen bieten kann. Hierzu zählt die Möglichkeit, neue Thriller und andere Bücher beim Händler auf Ihren Namen reservieren zu lassen oder eine Bestellung bei ihm zu tätigen. In Ihrem Reservierungsstatus
können Sie anschließend jederzeit überprüfen, ob Ihre Bestellungen beim Händler eingetroffen sind, wodurch Sie sich unnötige Wege ersparen. Sehr nützlich ist auch der genialokal-Merkzettel, auf dem Sie jederzeit die Titel interessanter neuer Thriller speichern können, um sie gegebenenfalls später zu bestellen. Übrigens: Über Ihr genialokal Nutzerkonto können Sie auch eBook-Käufe zum sofortigen Download abwickeln oder sich Ihre Bestellungen bequem per Post nach Hause liefern lassen.
Warum Sie neue Thriller lokal einkaufen sollten
Mit dem Aufkommen des Internets ist der Konkurrenzdruck für die bewährten Buchläden gestiegen, denn viele Menschen schätzen die Möglichkeit, ihre Medien mit wenigen Mausklicks bestellen zu können. Dass hierdurch gewachsene, lebendige Wirtschaftsstrukturen in der Region nach und nach veröden, ist vielen Verbrauchern gar nicht bewusst. Die längerfristigen Folgen sind, dass nicht nur die regionale Versorgungssicherheit leidet, sondern auch viele wertvolle Arbeits- und Ausbildungsplätze verloren gehen. Am Ende dieser Entwicklung stehen verwaiste Innenstädte und wehmütige Erinnerungen an bessere Zeiten.
Damit es nicht so weit kommt, ist es empfehlenswert, verantwortungsbewusste Einkaufsentscheidungen zu treffen. Kaufen Sie neue Thriller also am besten dort, wo man sich noch dem einzelnen Kunden verpflichtet fühlt: beim lokalen Buchhändler. Damit Sie auf die Vorteile des Internets dennoch nicht verzichten müssen, hilft Ihnen genialokal bei der Vernetzung mit dem regionalen Buchhandel. Profitieren Sie von persönlichem Service, individueller Beratung und nicht zuletzt auch von den Beiträgen örtlicher Anbieter zur regionalen Kultur. Nicht selten tritt gerade die Buchhandlung vor Ort als engagierter Veranstalter stimmungsvoller Autorenlesungen auf oder beteiligt sich aktiv an der Leseförderung in Schulen. All diese Leistungen jenseits des reinen Tagesgeschäfts können gar nicht hoch genug eingeschätzt werden, wenn wir uns ein kulturell lebenswertes Umfeld erhalten wollen.
 Und dann auf "Zum Home-Bildschirm [+]".
Und dann auf "Zum Home-Bildschirm [+]".